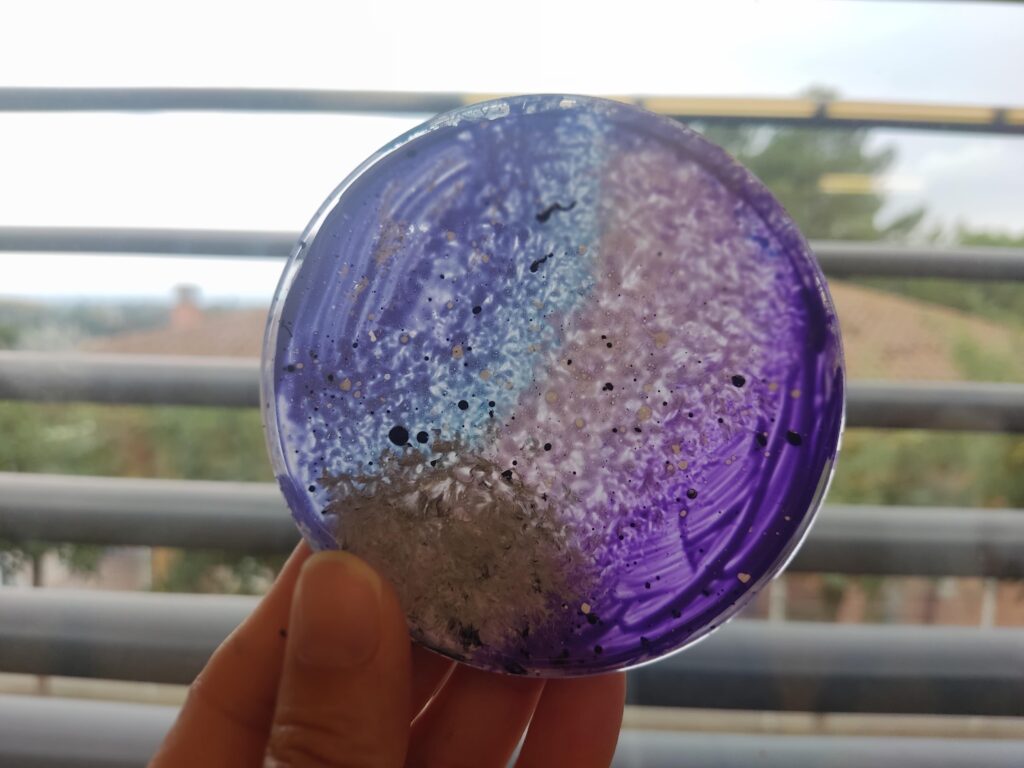

Aquest mes de gener l’alumnat de 5è i 6è hem finalitzat la primera roda de tallers d’art, lligats al projecte de medi: “els cinc regnes dels éssers vius”.
Vam iniciar-los a través de la caixa d’autor de Martín Azúa, cedida per part del museu d’art La Panera, de Lleida.
Aquest dissenyador ens va apropar als conceptes de natural-artificial, on vam dur a terme creacions d’art efímer. A més, vam aprendre la tècnica del frottage per després fer les nostres pròpies composicions.
Un altre dels tallers va anar dirigit a treballar el regne vegetal, tot confeccionant el nostre propi herbari d’Alguaire. Treballant des de l’observació directa de cada planta i flor del nostre entorn, amb delicadesa, fent els traços a llapis per deixar-ho plasmat al paper.
En el següent taller ens vam envoltar de plaques de petri i mini móns bacteriològics. Gràcies a l’artista Klari Reis vam poder observar que la microbiologia també pot esdevenir art!
L’últim taller va anar dirigit a treballar el regne animal, des de la perspectiva d’Emily Robertson. Les vivències de l’artista en la vida de camp i l’amor per la impressió de tall de linó han permès crear unes produccions artístiques, amb la tècnica del carvat, molt “animals”.
Properament, obrirem la instal·lació artística a les famílies de cicle superior, us hi esperem! ♥

Un taller genial. Amb tècniques i procediments diferents. Una gran oportunitat.
Quin gust aprendre tocant, observant i experimentant!!